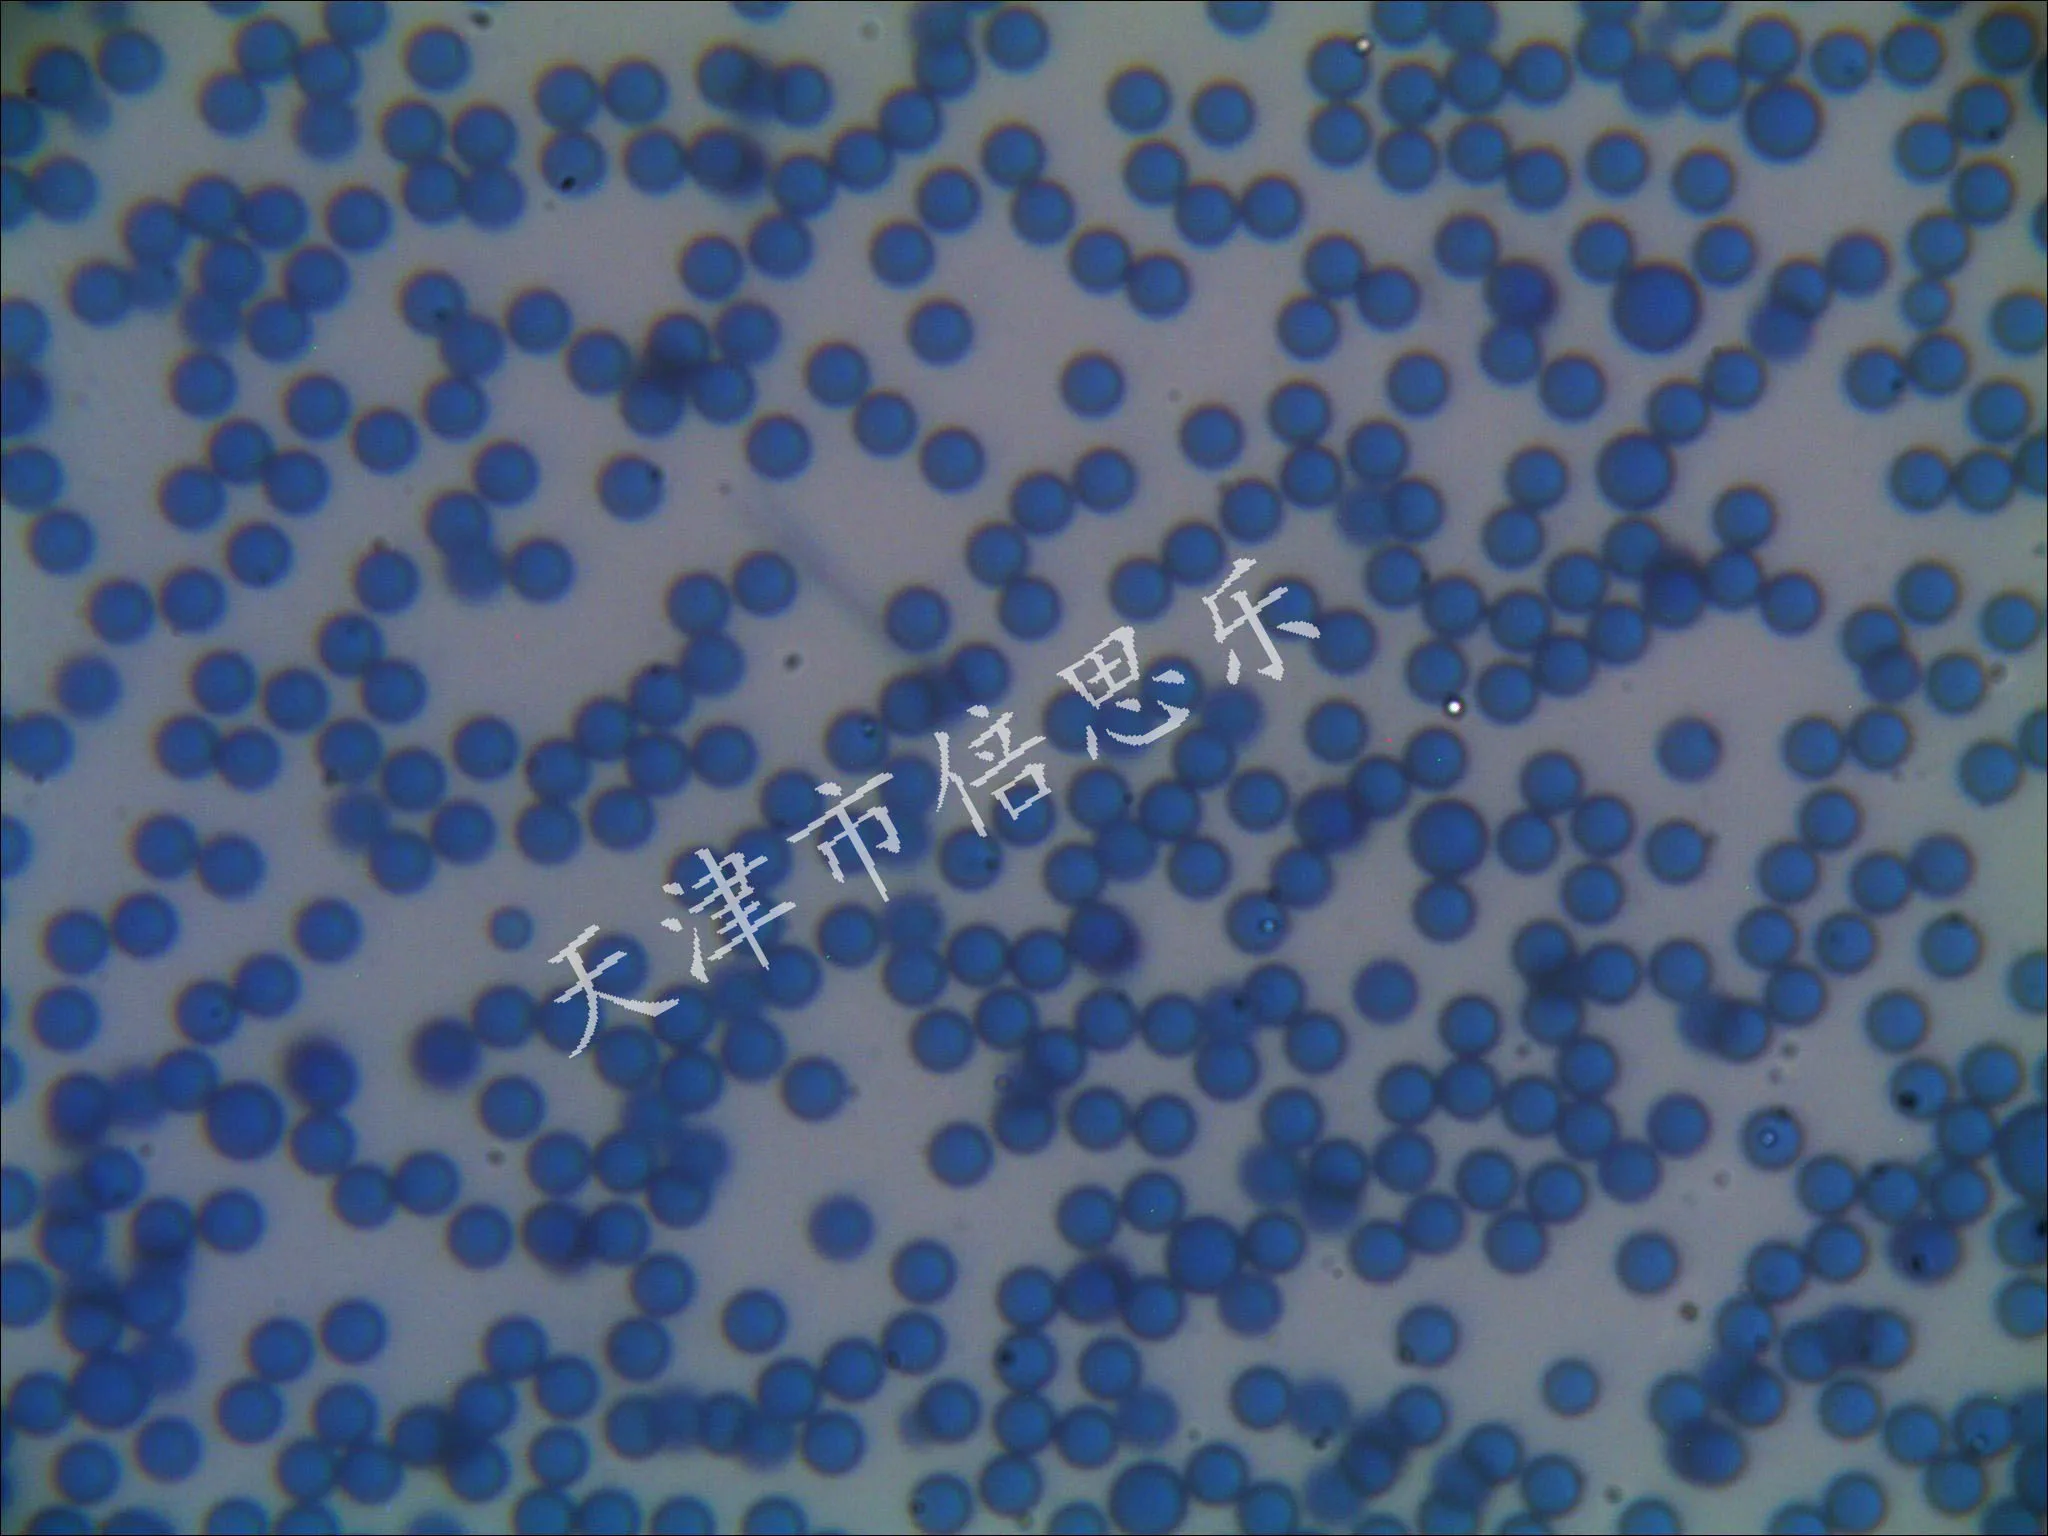
Монодисперсные цветные латексные микросферы/красный синий желтый
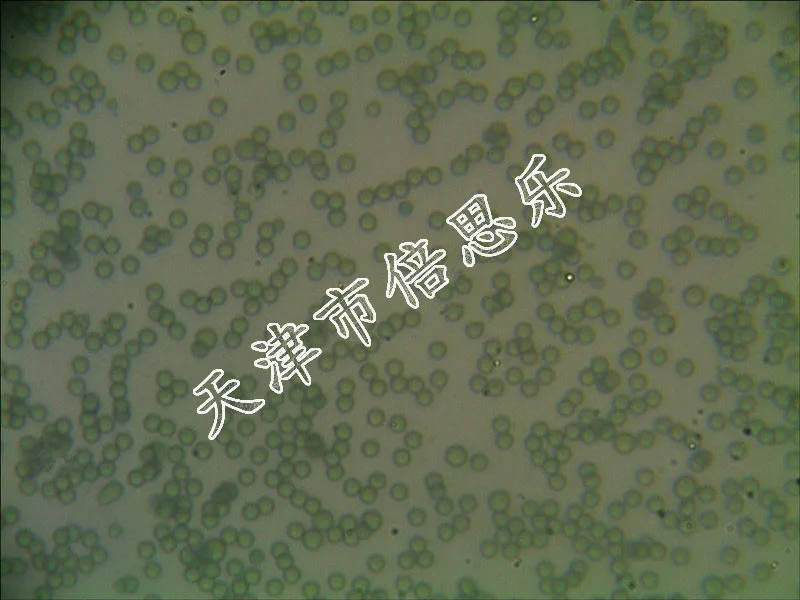
Монодисперсные цветные латексные микросферы/красный синий желтый
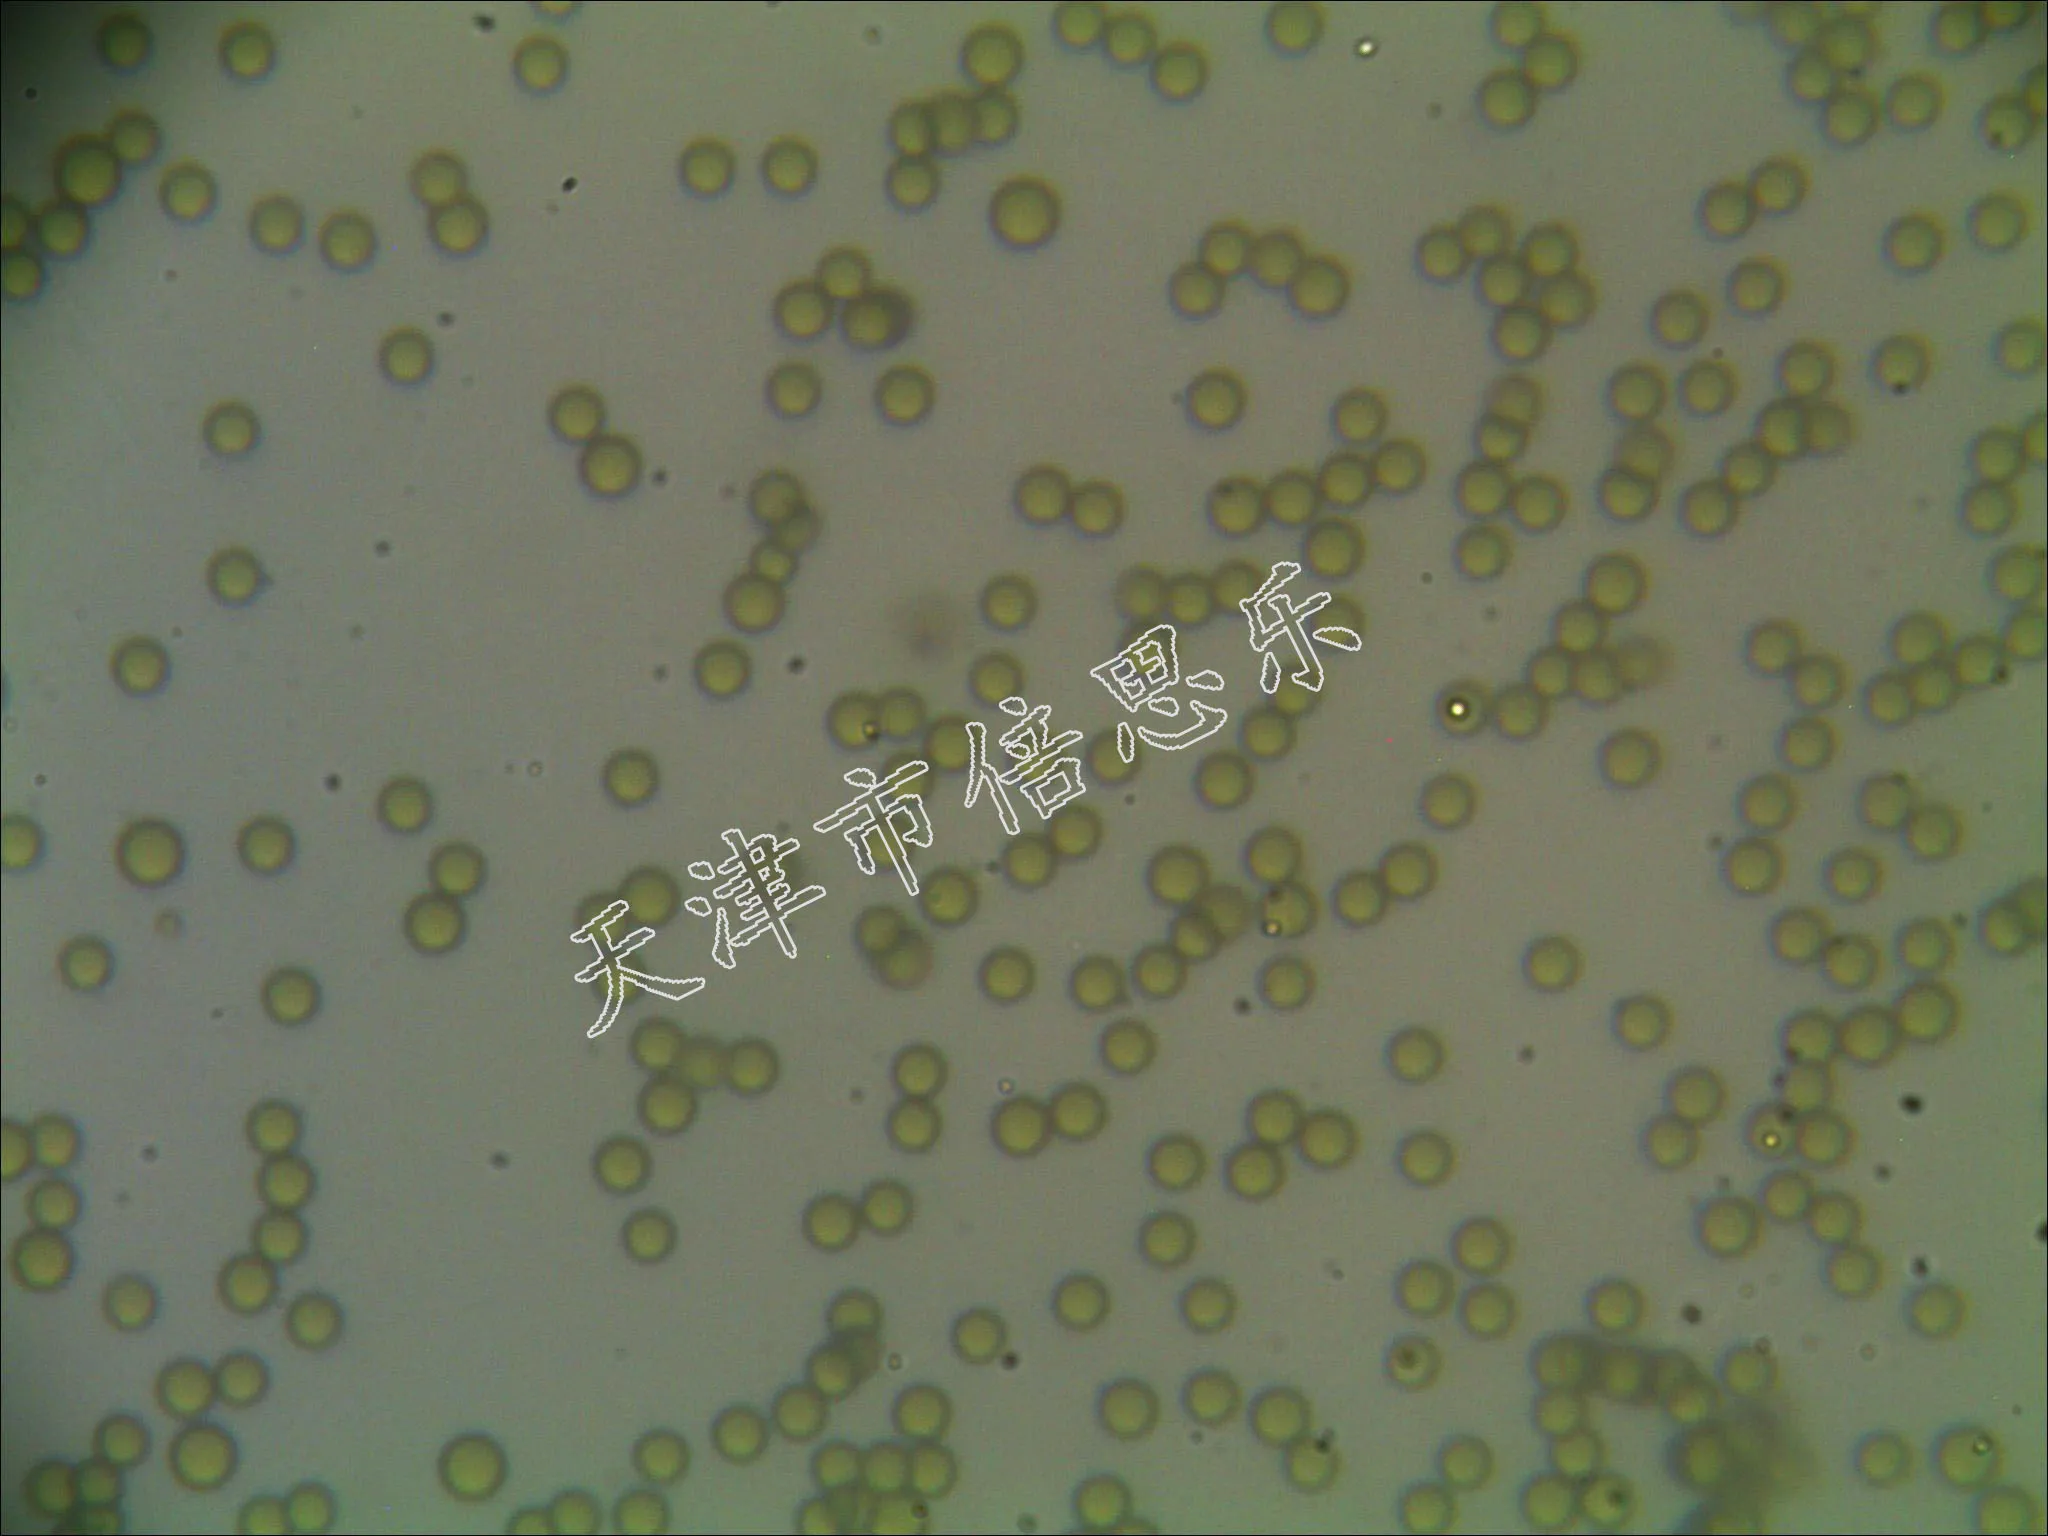
Монодисперсные цветные латексные микросферы/красный синий желтый

Монодисперсные цветные латексные микросферы/красный синий желтый
Сохраните в закладки:





История цены
*История изменения цены! Указанная стоимость возможно, уже изменилось. Проверить текущую цену - >
| Месяц | Минимальная цена | Макс. стоимость | Цена |
|---|---|---|---|
| Feb-21-2026 | 11243.20 руб. | 11468.49 руб. | 11355.5 руб. |
| Jan-21-2026 | 9119.96 руб. | 9301.14 руб. | 9210 руб. |
| Dec-21-2025 | 11066.97 руб. | 11287.24 руб. | 11176.5 руб. |
| Nov-21-2025 | 10978.49 руб. | 11198.57 руб. | 11088 руб. |
| Oct-21-2025 | 8764.40 руб. | 8939.66 руб. | 8851.5 руб. |
| Sep-21-2025 | 10801.32 руб. | 11017.17 руб. | 10909 руб. |
| Aug-21-2025 | 10712.81 руб. | 10926.48 руб. | 10819 руб. |
| Jul-21-2025 | 10624.98 руб. | 10836.29 руб. | 10730 руб. |
Новые товары
MFRC531 RFID (Радиочастотная Идентификация) RC531 радиочастотный модуль считыватель
1 шт. 1/4 дюймовый Реверсивный Мини-ключ двойной крутящий момент универсальный
PCM1808 ADC AUX 3 5 стерео одностороннее Аналоговое аудио для I2S цифровой интерфейс IIS
Регулируемый Магнитный Флип-датчик уровня модуль дистанционной передачи
Инструмент для зачистки проводов портативный инструмент обжимные плоскогубцы -
Садовый шланг 1/2 дюйма на 8 мм резьбовое соединение из нержавеющей стали, распылитель, поливочная система.
Садовый шланг насадки функциональный насадка для мытья новый высоконапорный распылитель воды автомобильная мойка очистительный пистолет.
Фонтанная насадка G1 дюйма DN25 Медь Многонаправленный прямой распылитель для ландшафтного озеленения.
Характеристики
Монодисперсные цветные латексные микросферы/красный синий желтый
Описание товара
Радужные монодисперсные латексные микросферы подготовлены путем сочетания хромофоров на матрице или поверхности микросферы из полистирола. Доступны с регулируемым размером частиц, начиная от нанометра до микрометра, монодисперсные латексные микросферы с различными функциональными группами и различными красителями цвета
Радужные латексные микросферы имеют характеристики ярких цветов, стабильную производительность и распределение узких размеров частиц. Они могут быть широко использованы в микроскопическом определении, иммуноанализа, агглютинационных реакций и других тестов.
Каждая партия нашей продукции проходит строгие проверки производства и проверки качества для обеспечения качества продукции.
Трекер стоимости
Отзывы покупателей
Новые отзывы о товарах
Делаю на заказ бусы, но такой темно-синий жемчуг вижу в продаже нечасто. Решила взять, чтобы предложить клиентам что-то необычное. Цвет... Читать отзыв полностью...
Купила такой диспенсер себе на кухню, очень удобный и недорогой, моется легко, грязь на дне не скапливается, потому что легко... Читать отзыв полностью...
Нереальная сумка??? Это просто моя любовь, тем более за свою цену. Больше она конечно подходит для весны и лета. Но... Читать отзыв полностью...
Взяла часы с лисичкой. Очень милые, нравятся и дочке, и мне. Дочка даже нарисовала эту лису в своем альбоме. Часы... Читать отзыв полностью...
Немного маломерит - берите побольше размер. Из минусов это все. Нереально красивый костюм. Идеально для домашней фотосессии, тем более для... Читать отзыв полностью...
Чехлы всегда покупаю в интернете. Гораздо дешевле, а качество один в один. В магазинах бешеная наценка. Возможно они сами и... Читать отзыв полностью...

Выбрала розовый вариант пижамки. Выглядит мило, романтично и немножко по-детски. На теле она приятная, ткань как невесомая. После первой стирки... Читать отзыв полностью...